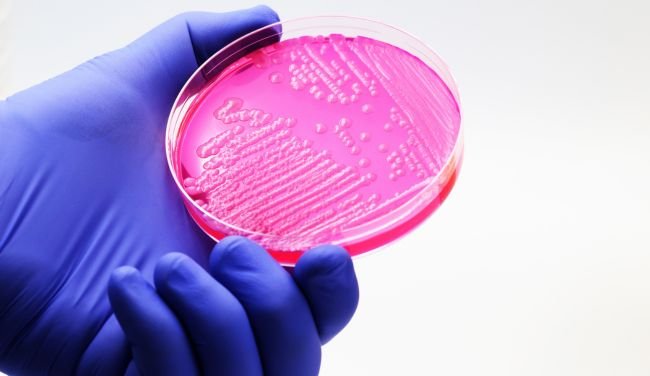
CME

Advanced Dermatology and Hair Care Education by Xpeer Medical Education, Supported by L'Oréal Dermatological Beauty Pro and SkinAlliance.
These educational offerings are meticulously crafted to enhance the expertise of healthcare professionals in these specialized fields, integrating cutting-edge research and innovative practices.
This activity is supported by unrestricted financial support from L'Oréal Dermatological Beauty Pro and SkinAlliance.
L'Oréal Dermatological Beauty Pro and SkinAlliance are not involved in the development of the course content.
Course Instructors: Dr. Araviiskaia, Dr. Bieber, Dr. Dreno, Dr. Vogt
Accredited Credit: 1 CME
Course Learning Objectives: